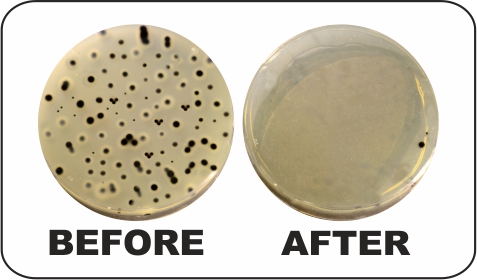
Awesome Image

-
Contact Us
+971 524263908, +971 4 5574172 -
Email
marketing@wetkem.com
About Us

Wet Kem Chemicals Trading LLC offers sustainable, smart and quantifiable solutions for specific needs through a comprehensive range of innovative and economical technologies and services such as:
- Complete water management with zero liquid discharge
- Solid Waste Management
- Industrial Wastewater /Effluent Treatment Plants
- Sewage Treatment Plants
- Raw Water Treatment Plants
- Demineralization Plants
- RO Plants
- Water Audit
Chemicals + Service = Profit

Cooling Water Treatment
- Antiscalant
- Biocides
- Polymeric Dispersants
- Chlorine Dioxide Treatment

Boiler Water Treatment
- Corrosion Inhibitor
- Oxygen Scavengers
- Antiscalant
- pH Controller

Effluent Treatment
- Flocculant
- Antifoam
- Ferrous Sulphate
- Alum

Water Treatment Plant
- Reverse Osmosis Plant
- Water Softener
- DM Plant
- ETP/STP (ZLD Plant)

Resins
- Strong/ weak acid cation
- Strong/ weak base anion
- Mixed bed

Fireside Chemicals
- Soot Deposit Cleaner
- Fuel Oil Combustion Improver
- Diesel Fuel Improver

Swimming Pool Chemicals
- TCCA-90
- Biocide
- pH Controller

Surfactants
- DOSS
- LABSA
- SLES
- Ethoxylates Based

On Site Chemical Testing

Online Monitoring Instrument
Biocides Treatment

Activated Carbon

Testing Kit

Corrosion Coupon

Heat Exchanger Cleaning

M.S.F
- Antifoam
- Antiscalent
- pH Booster

Oil Field Chemicals
- Scale Inhibitor
- Biocides
- Partially Hydrolyzed Agents
- Corrosion Inhibitor/Filming Amine
- Demulsifier
- OSD(Oil Spill Dispersants)
- PPD(Pour Point Disperssant)
- Neutralizing Amine

Service
- Water Analysis
- Online Chemical Cleaning
- PipeLine Pre-cleaning
- Corrosion Inhibitor/Filming Amine
- Corrosion Monitoring
.jpg)
Reverse Osmosis Chemicals
- Antiscalant
- pH Booster Chemicals
- De -Chlorination
- Descaling chemicals
- Biocides

Closed Loop System
- Corrosion Inhibitor
- Biocides


